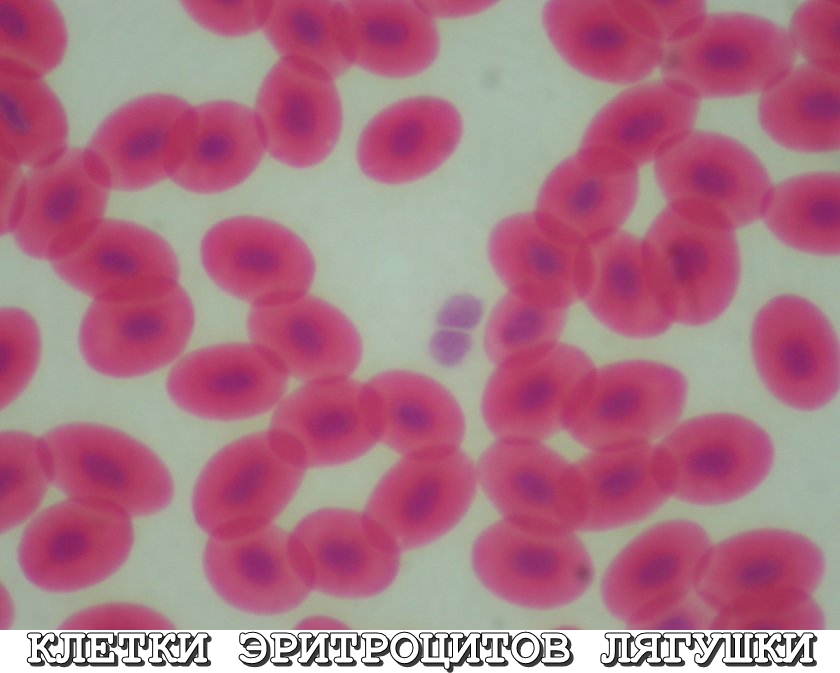

ПОМОГИТЕ ПОЖАЛУЙСТА!!! КИНЬТЕ ФОТО С ПОДПИСЯМИ: СТРОЕНИЕ ЛИСТА ЭЛОДЕИ,КЛЕТКИ ЭРИТРОЦИТОВ ЛЯГУШКИ...ЗАРАНЕЕ ПРИЗНАТЕЛЕН И БЛАГОДАРЕН ТЕМ,КТО ОТКЛИКНЕТСЯ:-)
Ответы
Ответ дал:
0
все что смогла)) но я точно не уверена)) удачи))
Приложения:

Вас заинтересует
3 года назад
3 года назад
8 лет назад
8 лет назад
11 лет назад
11 лет назад
11 лет назад